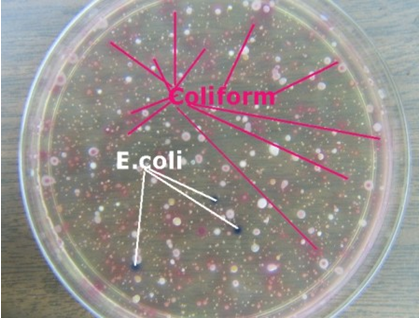

“การระบาดของเชื้อแบคทีเรีย อี โคไล โอ ๑๐๔ โรคติดต่ออุบัติใหม่แห่งปี ๒๕๕๔”
นายแพทย์รุ่งเรือง กิจผาติ
ผู้อำนวยการสำนักโรคติดต่ออุบัติใหม่
กรมควบคุมโรค กระทรวงสาธารณสุข
สถานการณ์การระบาดเชื้อแบคทีเรีย อี โคไล โอ ๑๐๔ (Enterohemorrhagic E. Coli: EHEC O104)
จากข่าวการระบาดของเชื้อแบคทีเรีย อี โคไล โอ ๑๐๔ ในประเทศเยอรมันนี ซึ่งเริ่มต้นตั้งแต่เดือนพฤษภาคม พ.ศ. ๒๕๕๔ มีรายงานผู้ป่วยแลผู้เสียชีวิตเพิ่มขึ้นเรื่อยๆ จนถึงข้อมูลล่าสุด รายงานสถานการณ์ฉบับที่ ๑๔ ขององค์การอนามัยโลก เมื่อวันที่ ๑๑ มิถุนายน พ.ศ. ๒๕๕๔ พบผู้ป่วย ๓๒๕๖ ราย และผู้เสียชีวิต ๓๗ ราย ใน ๑๖ ประเทศ (เยอรมัน ออสเตรีย สาธารณรัฐเช็ค เดนมาร์ค ฝรั่งเศส เนเธอร์แลนด์ นอรเวย์ โปแลนด์ สเปน สวีเดน กรีซ ลักเซมเบอร์ก สวิสเซอร์แลนด์ สหราชอาณาจักร สหรัฐอเมริกา แคนาดา) ผู้ป่วยเกือบทั้งหมด มีประวัติเดินทางไป/กลับเยอรมันในช่วงระยะฟักตัวของโรค นับตั้งแต่ได้รับเชื้อจนกระทั้งมีอาการป่วย คือ ๓ ถึง ๔ วัน (อาจพบได้ตั้งแต่ ๒ ถึง ๑๐ วัน) ผู้ป่วยที่พบส่วนใหญ๋เป็นเพศหญิง และมีอายุมากกว่า ๒๐ ปีขึ้นไป สำหรับผู้ป่วยที่ยกเว้น ๑ ราย มีประวัติสัมผัสกับผู้ป่วยจากเยอรมัน “การระบาดดังกล่าว สร้างความสพรึงกลัวไม่เพียงแต่คนไทยเท่านั้น แต่ทั่วโลกกำลังจับตากับมหันตภัยโรคติดต่ออุบัติใหม่แห่งปี ๒๕๕๔ นี้ ว่าจะจบลงอย่างไร”

ภาพแสดง ประเทศที่มีการระบาดของเชื้อ อี โคไล โอ ๑๗๔
เชื้อ อี โคไล (Escherichia coli: E. coli) และเชื้อ อี โคไล โอ ๑๐๔ คืออะไร
เชื้อ อี โคไล (Escherichia coli: E. coli) เป็นแบคทีเรียในกลุ่มโคลิฟอร์ม ที่มีอยู่ตามธรรมชาติ พบในลำไส้ใหญ่ของสัตว์และมนุษย์ สายพันธุ์ส่วนใหญ่ไม่ก่อโรคหรืออันตรายแก่มนุษย์ อีกทั้งยังมีประโยชน์ในการสร้างวิตามินเคในลำไส้ที่เป็นประโยชน์ให้แก่มนุษย์ สำหรับสายพันธุ์ที่ทำให้เกิดโรคนั้น ทำให้เกิดโรคติดเชื้อตามที่ต่างๆตามร่างกาย ผิวหนัง อวัยวะต่างๆ โรคติดเชื้อทางเดินปัสสาวะ ก่อให้เกิดโรคติดเชื้อทางเดินอาหารหรือโรคอุจจาระร่วง เช่น สายพันธุ์ Enterotoxigenic E. coli (ETEC) ซึ่งสร้างสารซึ่งเป็นพิษต่อระบบทางเดินอาหาร ทำให้ท้องเสีย, สายพันธุ์ Enteroinvasive E. coli (EIEC) ซึ่งรุกรานเซลล์เยื่อบุลำไส้ คล้ายโรคบิดจากเชื้อชิเกลลา ทำให้มีไข้สูง ท้องเสียรุนแรง, สายพันธุ์ Enterohemorrhagic E. coli (EHEC) ซึ่งสร้างสารพิษทำลายเยื่อบุลำไส้ ทำให้มีถ่ายเป็นเลือด เชื้อในกลุ่มนี้ที่เป็นที่รู้จักมากที่สุดคือเชื้อชนิด O157:H7 สร้างสายพิษ Shiga toxin (Shiga-toxin producing Escherichia coli หรือ STEC) สามารถทำให้เกิด Hemolytic-uremic syndrome และไตวายเฉียบพลัน
เชื้อ อี โคไล โอ ๑๐๔ (Enterohemorrhagic E. Coli: EHEC O104) ที่พบในขณะนี้ เป็นหนึ่งในสายพันธุ์ที่สร้าง Shiga toxin ทำให้เกิด Hemolytic-uremic syndrome และไตวายเฉียบพลันได้ (เช่นเดียวกับ เชื้อ อีโค ไล O157:H7) ซึ่งในปัจจุบันพบเชื้อ STEC มีมากกว่า ๑๐๐ O-Serotypes ก่อนจะมีการระบาดใน พ.ศ. 2554 มีการรายงานผู้ป่วย E. coli O104:H4 ตีพิมพ์ในวารสารวิชาการเพียงรายเดียว เป็นผู้ป่วยหญิงชาวเกาหลี ซึ่งรายงานไว้ใน พ.ศ. ๒๕๔๘
สถานการณ์การเฝ้าระวังในประเทศไทยตั้งแต่ปี พ.ศ. ๒๕๓๘ จนถึงปัจจุบัน (๑๒ มิถุนายน ๒๕๕๔)
จากข้อมูลสำนักระบาดวิทยา กรมควบคุมโรค รายงานว่า ไม่พบรายงานการระบาดของเชื้อแบคทีเรีย อี โคไล โอ ๑๐๔ ในประเทศไทย และข้อมูลการเฝ้าระวังทางห้องปฏิบัติการของกรมวิทยาศาสตร์การแพทย์ รายงานว่า ไม่เคยพบเชื้ออี โคไล โอ ๑๐๔ ในประเทศไทยเช่นกัน มีรายงานเพียงสายพันธุ์อื่นๆ (พบผู้ป่วย ๗ ราย และผู้สัมผัส ๑ ราย เช่น O๑๑๑, O๑๕๗, O8 เป็นต้น และที่ผ่านมา ไม่เคยพบรายงานการระบาดเป็นวงกว้าง มีแต่เพียงการพบผู้ป่วยเป็นรายๆ)
ขณะนี้ประเทศไทย รับมือกับเรื่องดังกล่าวอย่างไร
กรมควบคุมโรค ได้ติดตามสถานการณ์อย่างใกล้ชิดมาตั้งแต่เริ่มต้นการระบาด และได้รายงานกระทรวงสาธารณสุข ซึ่งได้สั่งการไปยังนายแพทย์สาธารณสุขทุกจังหวัด และประสานไปยังกรุงเทพมหานคร ให้ทุกหน่วยงานที่เกี่ยวข้องดำเนินการ ในระยะที่ยังไม่พบผู้ป่วยในประเทศไทย ด้วย ๔ มาตรการหลัก ดังนี้
มาตรการที่ ๑ “เฝ้าระวังผู้ป่วยเชื้อ อี โคไล โอ ๑๐๔”
สถานพยาบาลทุกแห่งเฝ้าระวังผู้ป่วยที่เดินทางมาจากทวีปยุโรป หรือผู้ที่คลุกคลีกับผู้ป่วยที่มีอาการท้องเสียและเพิ่งเดินทางกลับจากยุโรปใน ๗ วันก่อนวันเริ่มป่วย โดยเฝ้าระวังผู้ป่วยที่มีประวัติเสี่ยงดังกล่าวและมีอาการถ่ายเป็นเลือด หรือมีมูกเลือดปน หรือผู้ป่วยที่มีอาการปวดท้อง ร่วมกับถ่ายเหลว และตรวจพบเม็ดเลือดแดงและเม็ดเลือดขาวในอุจจาระมากกว่าปกติ รวมทั้งให้แพทย์เฝ้าระวังผู้ป่วยทีมีภาวะ Hemolytic Uremic Syndrome และมีประวัติท้องเสียนำมาก่อนเป็นพิเศษด้วย
หากพบผู้ป่วยเข้าข่ายดังกล่าว ให้รายงานเพื่อให้มีการสอบสวนโรค และส่งตรวจตัวอย่างอุจจาระที่ห้องปฏิบัติการโรงพยาบาล หากพบเชื้อ อี โคไล ให้ส่งต่อเชื้อที่พบไปยังห้องปฏิบัติการของกรมวิทยาศาสตร์การแพทย์ เพื่อตรวจหา Shiga toxin และเพื่อตรวจยืนยันเชื้อ อี โคไล โอ ๑๐๔ ต่อไป
ให้ทีมเฝ้าระวังสอบสวนเคลื่อนที่เร็ว ทำการสอบสวนผู้ป่วยต้องสงสัยทุกราย ทำลายเชื้อบริเวณที่ผู้ป่วยขับถ่าย เฝ้าระวังผู้สัมผัสผู้ป่วยเป็นระยะเวลา ๗ วัน รายงานมายังสำนักระบาดวิทยา กรมควบคุมโรค ภายใน ๒๔ ชั่วโมง และห้ามแจกยาปฏิชีวนะในชุมชนโดยเด็ดขาด
ภาพแสดง เชื้อ อี โค ไล ที่ตรวจพบจากการเพาะเชื้อ หลังจากนั้นให้ส่งต่อไปยังห้องปฏิบัติการกรมวิทยาศาสตร์การแพทย์ เพื่อทำการตรวจยืนยันเชื้อ
มาตรการที่ ๒ “เร่งรัดประชาสัมพันธ์ สื่อสารความเสี่ยงให้กับผู้เดินทาง ประชาชนทั่วไป”
หากท่านเพิ่งเดินทางกลับจากประเทศที่มีรายงานการพบผู้ป่วย และหลังออกจากประเทศดังกล่าวมีอาการดังต่อไปนี้ข้อใดข้อหนึ่งภายใน 7 วัน ได้แก่ อุจจาระเหลวเป็นน้ำ หรือมีเลือดปน หรือมีมูกเลือดปน หรือปวดท้อง อาเจียน ปัสสาวะออกน้อย หรือสงสัยว่ามีภาวะไตวาย เช่น ปริมาณปัสสาวะลดน้อยลงอย่างทันทีทันใด หรือหากท่านสัมผัสผู้ที่มีประวัติและอาการดังกล่าว หลังจากนั้นท่านมีอาการด้วย ให้รีบไปพบแพทย์ ณ โรงพยาบาลใกล้บ้านท่านทันที
นอกจากนี้ ได้มีการแจกคำแนะนำสำหรับผู้เดินทางเข้าประเทศจากประเทศที่มีรายงานผู้ป่วย หากมีอาการดังกล่าว ขอให้รีบไปพบแพทย์และแจ้งประวัติการเดินทางด้วย หรือแจ้งเจ้าหน้าที่ด่านควบคุมโรคติดต่อระหว่างประเทศเพื่อให้การช่วยเหลือต่อไป
คำแนะนำสำหรับประชาชน ขณะนี้ องค์การอนามัยโลก (WHO) ยังไม่ห้ามการเดินทางและขนส่งกับประเทศเยอรมันและประเทศที่มีการระบาด อย่างไรก็ตาม หากท่านมีความจำเป็นต้องเดินทางไป/กลับ ต่างประเทศ โดยเฉพาะอย่างยิ่ง ประเทศที่มีการระบาด ขอให้เลือกรับประทานอาหารที่ปรุงสุกใหม่ และล้างมือบ่อยๆ และหากเกิดอาการปวดท้อง ถ่ายเหลวเป็นเลือด ให้รีบไปพบแพทย์ทันที พร้อมแจ้งประวัติเสี่ยงให้ทราบ ท่านสามารถรับประทานน้ำเกลือแร่เพื่อทดแทนการสูญเสียน้ำในร่างกายได้ แต่ไม่ควรรับประทานยาระงับการถ่ายหรือยาปฏิชีวนะเอง เนื่องจากอาจทำให้อาการแย่ลงได้
รับประทานอาหารที่สะอาด ปรุงสุกด้วยความร้อนและปรุงสุกใหม่ๆ หรืออุ่นร้อนก่อนรับประทาน เนื่องจากความร้อนที่สูงกว่า 70 องศาเซลเซียส สามารถทำลายเชื้อได้ สำหรับอาหารค้างมื้อก่อนกินควรอุ่นให้เดือดทั่วถึงก่อนทุกครั้ง ไม่ควรกินอาหารดิบๆ สุกๆ เลือกใช้วัตถุดิบที่สะอาดและสด ใหม่ ในการประกอบอาหาร
ล้างผัก ผลไม้ เพื่อลดสิ่งปนเปื้อน ผัก ผลไม้ที่ซื้อมาจากตลาด หรือซุปเปอร์มาร์เก็ต ควรนำมาล้างก่อน โดยอาจใช้วิธีใดวิธีหนึ่งดังต่อไปนี้
• ลอกหรือปอกเปลือกชั้นนอกของผักสดหรือผลไม้ออกทิ้ง แกะเป็นกลีบหรือแกะใบออกจากต้นหรือตัดส่วนขอบรอบนอกแล้วแช่น้ำสะอาด นานประมาณ 10 – 15 นาที
• ล้างผักด้วยน้ำสะอาดหลายๆ ครั้งและคลี่ใบถู หรือล้างด้วยการเปิดน้ำไหลจากก๊อกแรงพอประมาณให้ไหลผ่านผักสด อย่างน้อย 2 นาที หรือใช้สารละลายอื่นๆในการล้าง เช่น น้ำส้มสายชู , เกลือ เป็นต้น
• แยกประกอบอาหารระหว่างวัตถุดิบที่นำมาประกอบอาหารชนิดดิบและที่ปรุงสุกแล้ว
ล้างมือให้สะอาดด้วยน้ำและสบู่ก่อนปรุงอาหาร ก่อนรับประทานอาหาร ก่อนใช้มือหยิบอาหารป้อนเด็ก และหลังใช้ห้องน้ำ – ห้องส้วม ทุกครั้ง เนื่องจากแบคทีเรียสามารถติดต่อและผ่านทางอาหารและน้ำ
ภาชนะที่ใช้รับประทานอาหารและดื่มน้ำ ต้องทำความสะอาดและเก็บไว้ในที่มิดชิดไม่ให้แมลงวันตอม ใช้ฝาชีครอบอาหารหรือนำใส่ตู้กับข้าวป้องกันแมลงวันตอมอาหาร เก็บถนอมอาหารไว้ในตู้เย็น ไม่ควรวางทิ้งไว้ข้างนอกนานเกิน 2 ชั่วโมง
ดื่มน้ำที่สะอาด เช่น น้ำต้มสุก น้ำดื่มบรรจุขวดที่ได้มาตรฐาน และเลือกซื้อน้ำแข็งรับประทานที่ถูกหลักอนามัย
ใช้ฝาปิดถังขยะ และกำจัดขยะมูลฝอยสิ่งปฏิกูลเพื่อไม่ให้เป็นแหล่งเพาะพันธุ์ของแมลงวัน และถ่ายอุจจาระในห้องส้วม
ให้ใช้ “โอกาสที่เกิดขึ้น เป็นโอกาสที่ดีในการเน้นย้ำ พัฒนาพฤติกรรมสุขภาพที่ดีของคนไทย”
มาตรการที่ ๓ “ให้การดูแลผู้ป่วย อย่างถูกต้อง รวดเร็ว”
โรงพยาบาล สถานพยาบาล ทั้งภาครัฐและเอกชน และแพทย์ตระหนักถึงผู้ป่วยที่มีความเสี่ยงการติดเชื้อโรคจากแบคทีเรีย อี โคไล โอ ๑๐๔ ให้ซักประวัติเสี่ยง หากพบเข้าข่ายสงสัยให้แจ้งทีมป้องกันควบคุมโรคในโรงพยาบาล ให้เก็บอุจจาระส่งตรวจที่ห้องปฏิบัติการโรงพยาบาล และห้ามให้ยาหยุดถ่าย ให้การรักษาตามแนวทางการรักษาผู้ติดเชื้อแบคทีเรีย อี โคไล O 104 การให้ยาปฏิชีวนะให้แพทย์พิจารณาตามความจำเป็นและเหมาะสม ให้ดูแลรักษาและระมัดระวังภาวะแทรกซ้อน ได้แก่ ภาวะเม็ดเลือดแดงแตก เกร็ดเลือดต่ำ และไตวาย หากมีความจำเป็น ให้ปรึกษาแพทย์ที่ปรึกษาในกรณีเกิดภาวะแทรกซ้อนดังกล่าว
มาตรการที่ ๔ “ประสาน เฝ้าระวัง และติดตามสถานการณ์อย่างใกล้ชิด”
กระทรวงสาธารณสุข มอบหมายให้กรมควบคุมโรค โดยผู้บริหารและผู้ทรงคุณวุฒิ (สำนักระบาดวิทยา สำนักโรคติดต่อทั่วไป สำนักโรคติดต่ออุบัติใหม่ สำนักเผยแพร่และประชาสัมพันธ์) เป็นคณะทำงานหลักด้านยุทธศาสตร์ วิชาการ และด้านประสานบริหารจัดการภาวะปกติและภาวะฉุกเฉิน ร่วมกับกรมวิทยาศาสตร์การแพทย์ กรมการแพทย์ กรมอนามัย สำนักงานคณะกรรมการอาหารและยา ประชุมติดตามสถานการณ์อย่างใกล้ชิด
หากพบการระบาดในประเทศไทยจริง เราจะทำอย่างไร คาดว่าจะรับมือได้หรือไม่
แม้ว่าองค์การอนามัยโลกได้รายงาน สถานการณ์การระบาดของเชื้อ อี โคไล โอ ๑๐๔ มีแนวโน้มดีขึ้น แต่หากมีการระบาดของเชื้ออี โคไล โอ ๑๐๔ ในประเทศไทย มาตรการทั้ง ๔ ข้อ จะต้องถูกปรับเปลี่ยนให้เข้มงวด มีความเหมาะสมกับสถานการณ์มากยิ่งขึ้น เช่น การติดตามผู้สัมผัสผู้ป่วยและควบคุมการระบาดอย่างทันท่วงที มาตรการเข้มข้นด้านสุขอนามัยและสิ่งแวดล้อม ในพื้นที่ที่พบผู้ป่วยและพื้นที่อื่นๆ การเร่งค้นหาผู้ป่วย พาหะ และเร่งให้การรักษาหรือควบคุมการแพร่เชื้อ มาตรการเข้มข้นในการควบคุมแหล่งรังโรค รวมถึงมาตรการเฉพาะกิจอื่นๆ ภายใต้การพิจารณาของคณะกรรมการด้านยุทธศาสตร์
หากเกิดการระบาดของเชื้อ อี โคไล โอ 104 ขึ้นจริง น่าเชื่อว่า จะสามารถควบคุมโรคให้สงบได้ และไม่เป็นปัญหาสำคัญด้านสาธารณสุขของประเทศ เนื่องจาก ประเทศไทยมีความพร้อมและประสบการณ์ในการรับมือการระบาดของโรคติดต่ออุบัติใหม่ เช่น การระบาดของโรคซาร์ส ไข้หวัดนก ไข้หวัดใหญ่สายพันธุ์ใหม่ ๒๐๐๙ อย่างไรก็ตาม คณะทำงานที่เป็นเครือข่ายทั้งภายในและนอกกระทรวงสาธารณสุข จะใช้ “โอกาสดังกล่าว เป็นโอกาสในการพัฒนา ปรับปรุง สร้างเสริมศักยภาพ “ระบบเฝ้าระวัง ป้องกัน และตอบโต้โรคติดต่ออุบัติใหม่ของประเทศ”
หากมีข้อสงสัยสงสัย หรือต้องการทราบข้อมูลเพิ่มเติม สามารถติดต่อสอบถามได้ที่ โทรศัพท์ 02-590-3333 หรือ 1422 กรมควบคุมโรค กระทรวงสาธารณสุข www.ddc.moph.go.th<
- Login to post comments
- อ่าน 2,593 ครั้ง
พิมพ์หน้านี้



